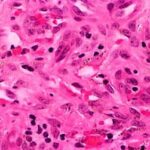

Stasis Dermatitis = التهاب الجلد الركودي
Stasis Dermatitis
Patients with long-standing venous insufficiency and lower extremity edema may develop pruritic, erythematous, scaly papules and plaques on the lower legs, often in association with brown pigmentation and hair loss. Ulceration is a frequent complication of long-standing stasis dermatitis.
Histopathology.
The variable epidermis may be hyperkeratotic with focal parakeratosis, acanthotic to atrophic, and with focal spongiosis. There is proliferation of small blood vessels in the papillary dermis, forming lobular aggregates {glomeruloid proliferation}. The proliferation may be florid, mimicking Kaposi’s sarcoma {acroangiodermatitis} . There is a superficial perivascular lymphocytic infiltrate that surrounds thickened capillaries and venules. The reticular dermis is often fibrotic. Extravasated erythrocytes and hemosiderin are usually present superficially, but they may be identified about the deep vascular plexus as well. Fibrin thrombi may be observed in the small vessels, likely reflecting flow disruption and anoxia. They do not indicate a concurrent coagulopathy. Endothelial necrosis and neutrophils may be present as well, reflecting similar changes, and do not indicate a leukocytoclastic vasculitis